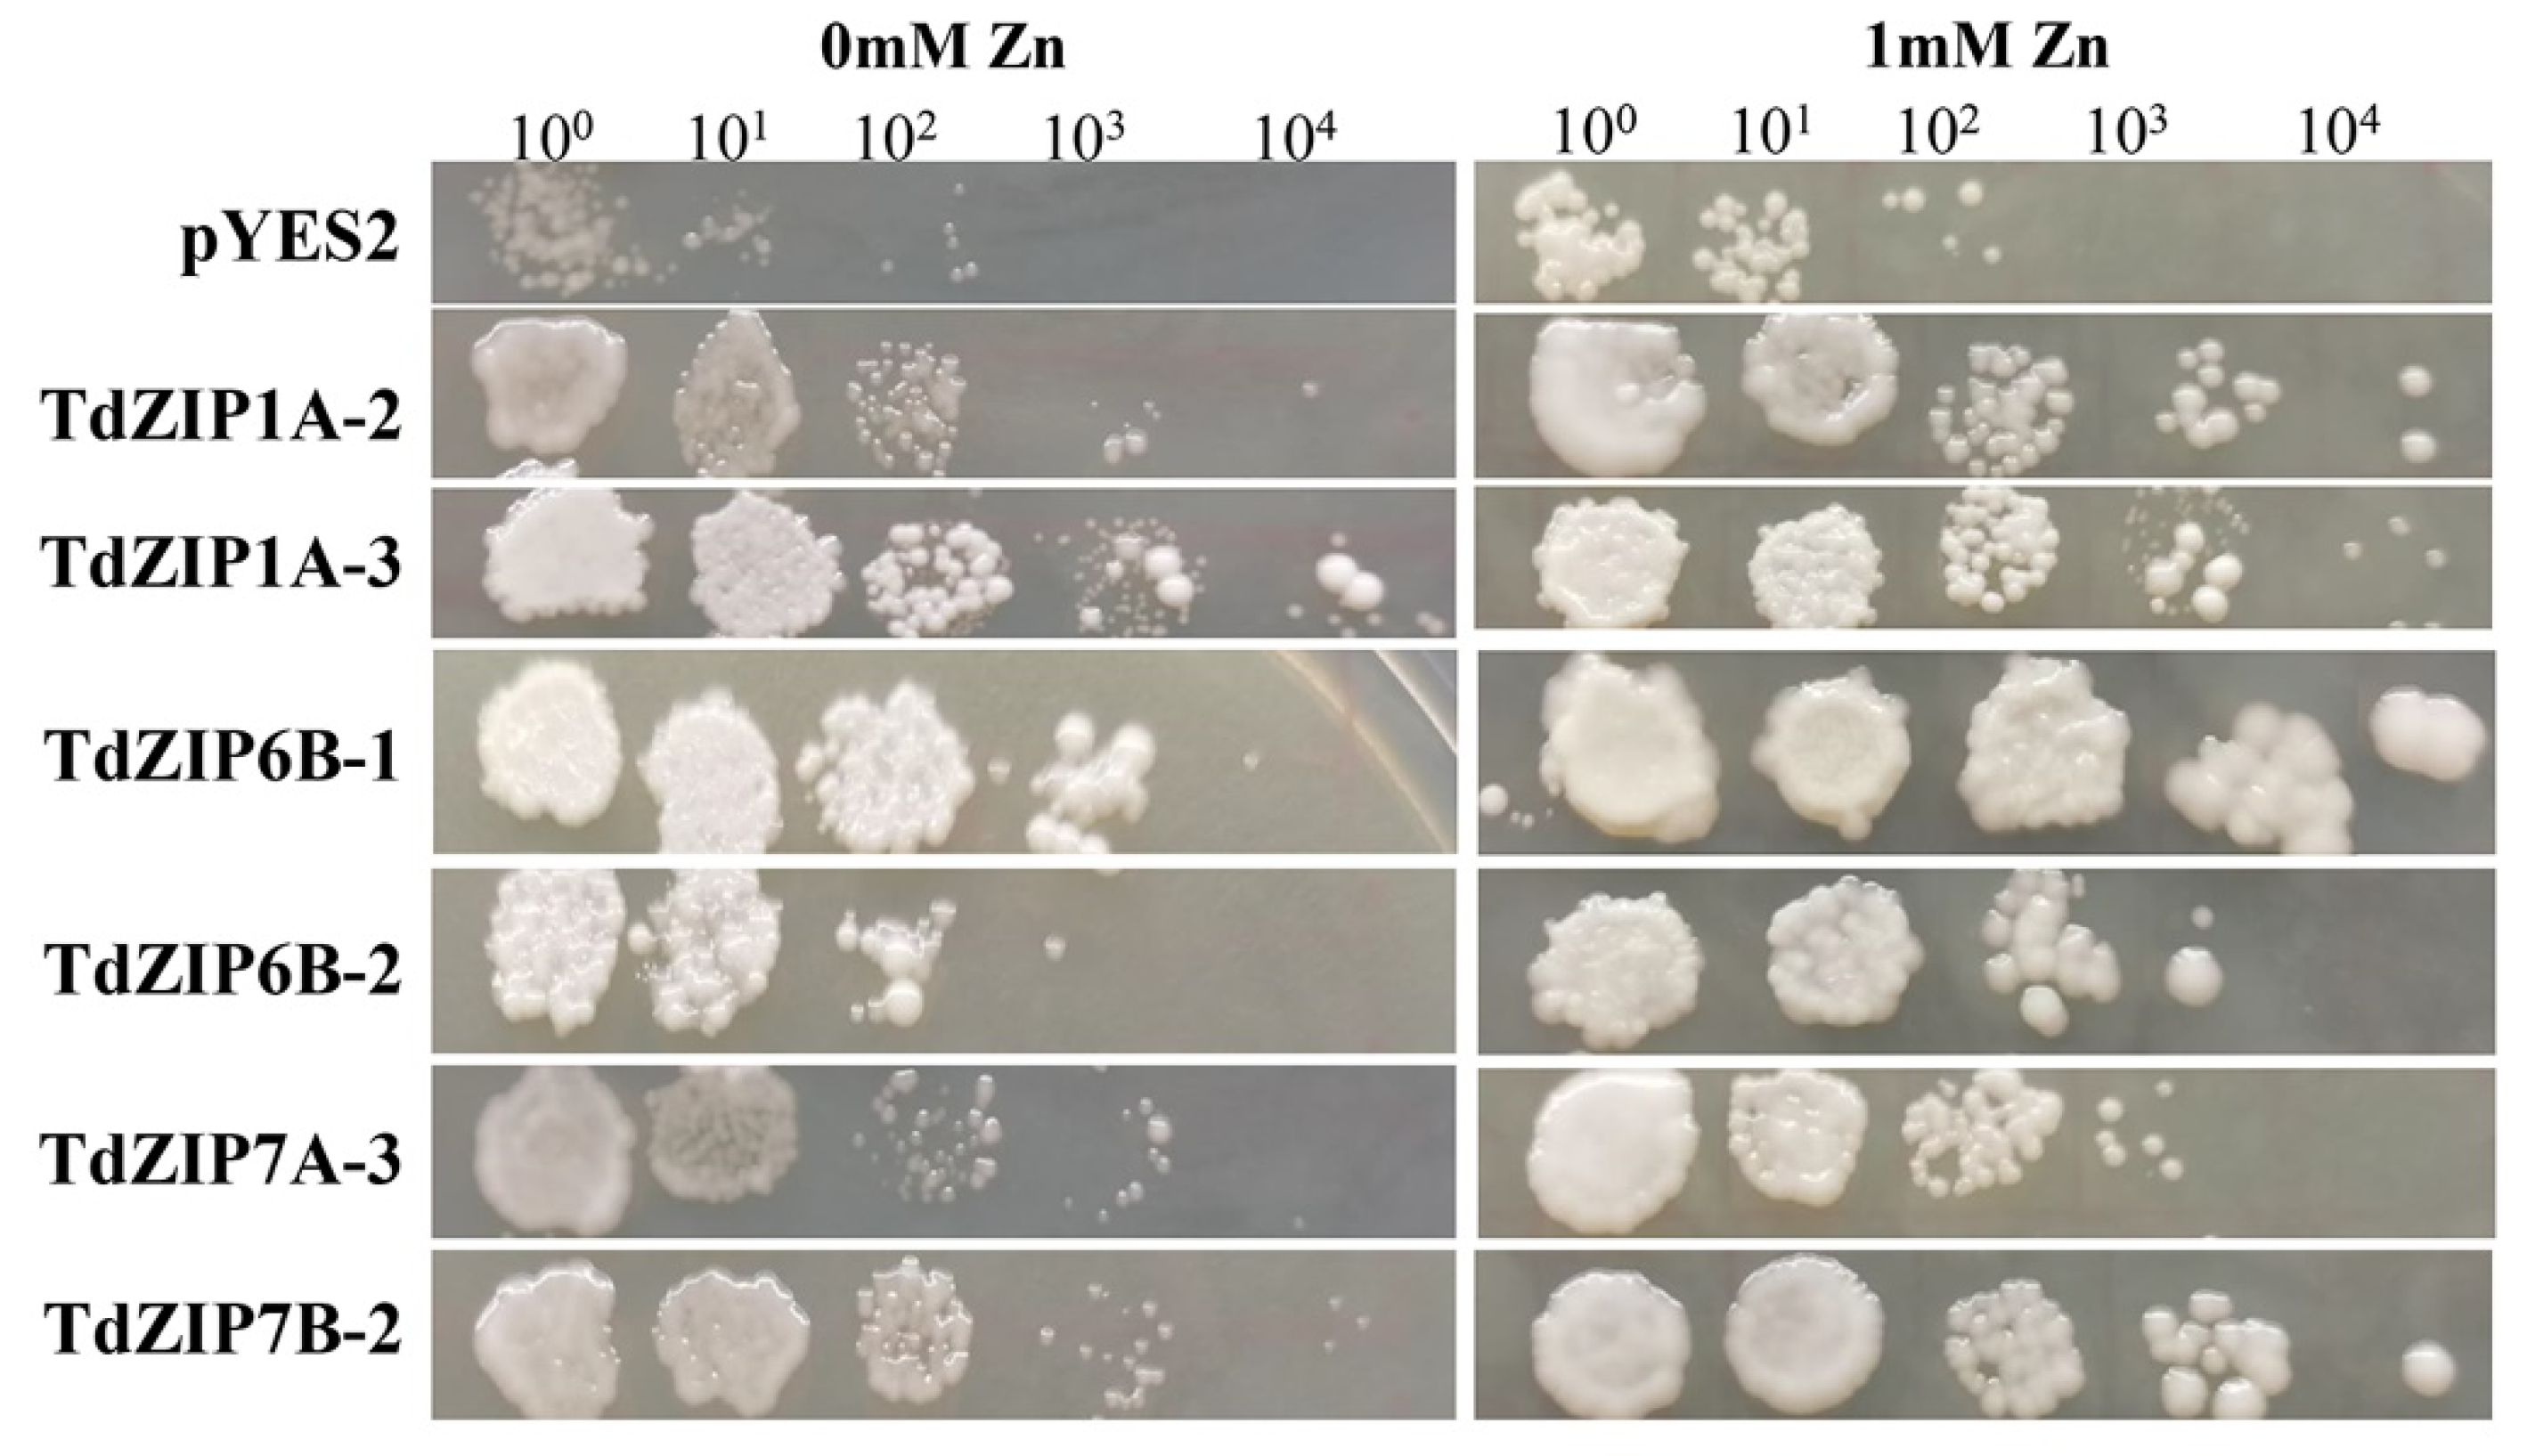

Genome-Wide Investigation and Functional Verification of the ZIP Family Transporters in Wild Emmer Wheat
Abstract
:1. Introduction
2. Results
2.1. Phylogenetic Relationships and Comparative Analysis of the ZIP Gene Family in Wild Emmer Wheat
2.2. Functional Annotation and Promoter Analysis of TdZIP Genes
2.3. Expression Pattern of TdZIP Genes under Zn-Deficient Stress
2.4. Yeast Complementation Analysis
2.5. Analysis of Phenotypes and Metal Concentrations in TdZIP6B-1 Overexpression Rice Plants
3. Discussion
4. Materials and Methods
4.1. Identification and Bioinformatic Analysis of TdZIP Genes
4.2. Gene Annotation and Cis-Element Analysis of TdZIPs
4.3. Plant Materials and Zn-Deficient Treatments
4.4. RNA Extraction and Quantitative Real-Time PCR (qRT-PCR)
4.5. Yeast Complementation Assay
4.6. Rice Transformation
4.7. Measurement of Metal Concentration
5. Conclusions
Supplementary Materials
Author Contributions
Funding
Institutional Review Board Statement
Informed Consent Statement
Data Availability Statement
Conflicts of Interest
References
- Haydon, M.J.; Cobbett, C.S. Transporters of ligands for essential metal ions in plants. New Phytol. 2007, 174, 499–506. [Google Scholar] [CrossRef] [PubMed]
- Krithika, S.; Balachandar, D. Expression of zinc transporter genes in rice as influenced by zinc-solubilizing Enterobacter cloacae strain ZSB14. Front. Plant Sci. 2016, 7, 446. [Google Scholar] [CrossRef] [PubMed] [Green Version]
- Broadley, M.R.; White, P.J.; Hammond, J.P.; Zelko, I.; Lux, A. Zinc in plants. New Phytol. 2007, 173, 677–702. [Google Scholar] [CrossRef] [PubMed]
- Ajeesh Krishna, T.P.; Maharajan, T.; Victor Roch, G.; Ignacimuthu, S.; Antony Ceasar, S. Structure, function, regulation and phylogenetic relationship of ZIP family transporters of plants. Front. Plant Sci. 2020, 11, 662. [Google Scholar] [CrossRef]
- Cakmak, I. Enrichment of cereal grains with zinc: Agronomic or genetic biofortification? Plant Soil 2008, 302, 1–17. [Google Scholar] [CrossRef]
- Kumssa, D.B.; Joy, E.J.M.; Ander, E.L.; Watts, M.J.; Young, S.D.; Walker, S.; Broadley, M.R. Dietary calcium and zinc deficiency risks are decreasing but remain prevalent. Sci. Rep. 2015, 5, 10974. [Google Scholar] [CrossRef] [Green Version]
- Liu, J.; Huang, L.; Wang, C.Q.; Liu, Y.X.; Yan, Z.H.; Wang, Z.Z.; Xiang, L.; Zhong, X.Y.; Gong, F.Y.; Zheng, Y.L.; et al. Genome-wide association study reveals novel genomic regions associated with high grain protein content in wheat lines derived from wild emmer wheat. Front. Plant Sci. 2019, 10, 464. [Google Scholar] [CrossRef]
- Tiong, J.; McDonald, G.; Genc, Y.; Shirley, N.; Langridge, P.; Huang, C.Y. Increased expression of six ZIP family genes by zinc (Zn) deficiency is associated with enhanced uptake and root-to-shoot translocation of Zn in barley (Hordeum vulgare). New Phytol. 2015, 207, 1097–1109. [Google Scholar] [CrossRef]
- Eide, D.J. Zinc transporters and the cellular trafficking of zinc. Biochim. Biophys. Acta 2006, 1763, 711–722. [Google Scholar] [CrossRef] [Green Version]
- Olsen, L.I.; Palmgren, M.G. Many rivers to cross: The journey of zinc from soil to seed. Front. Plant Sci. 2014, 5, 30. [Google Scholar] [CrossRef] [Green Version]
- Ishimaru, Y.; Suzuki, M.; Kobayashi, T.; Takahashi, M.; Nakanishi, H.; Mori, S.; Nishizawa, N.K. OsZIP4, a novel zinc-regulated zinc transporter in rice. J. Exp. Bot. 2005, 56, 3207–3214. [Google Scholar] [CrossRef] [PubMed]
- Lee, S.; Jeong, H.J.; Kim, S.A.; Lee, J.; Guerinot, M.L.; An, G. OsZIP5 is a plasma membrane zinc transporter in rice. Plant Mol. Biol. 2010, 73, 507–517. [Google Scholar] [CrossRef]
- Guerinot, M.L. The ZIP family of metal transporters. Biochim. Biophys. Acta-Biomembr. 2000, 1465, 190–198. [Google Scholar] [CrossRef] [Green Version]
- Pence, N.S.; Larsen, P.B.; Ebbs, S.D.; Letham, D.L.; Lasat, M.M.; Garvin, D.F.; Kochian, L.V. The molecular physiology of heavy metal transport in the Zn/Cd hyperaccumulator Thlaspi caerulescens. Proc. Natl. Acad. Sci. USA 2000, 97, 4956–4960. [Google Scholar] [CrossRef] [PubMed] [Green Version]
- Sasaki, A.; Yamaji, N.; Mitani-Ueno, N.; Kashino, M.; Ma, J.F. A node-localized transporter OsZIP3 is responsible for the preferential distribution of Zn to developing tissues in rice. Plant J. 2015, 84, 374–384. [Google Scholar] [CrossRef] [PubMed] [Green Version]
- Tan, L.T.; Zhu, Y.X.; Fan, T.; Peng, C.; Wang, J.R.; Sun, L.; Chen, C.Y. OsZIP7 functions in xylem loading in roots and inter-vascular transfer in nodes to deliver Zn/Cd to grain in rice. Biochem. Biophys. Res. Commun. 2019, 512, 112–118. [Google Scholar] [CrossRef]
- Yang, X.; Huang, J.; Jiang, Y.; Zhang, H.S. Cloning and functional identification of two members of the ZIP (Zrt, Irt-like protein) gene family in rice (Oryza sativa L.). Mol. Biol. Rep. 2009, 36, 281–287. [Google Scholar] [CrossRef]
- Grotz, N.; Fox, T.; Connolly, E.; Park, W.; Guerinot, M.L.; Eide, D. Identification of a family of zinc transporter genes from Arabidopsis that respond to zinc deficiency. Proc. Natl. Acad. Sci. USA 1998, 95, 7220–7224. [Google Scholar] [CrossRef] [Green Version]
- Kavitha, P.G.; Kuruvilla, S.; Mathew, M.K. Functional characterization of a transition metal ion transporter, OsZIP6 from rice (Oryza sativa L.). Plant Physiol. Biochem. 2015, 97, 165–174. [Google Scholar]
- Maurya, S.; Vishwakarma, A.K.; Dubey, M.; Shrivastava, P.; Shrivastava, R.; Chandel, G. Developing gene-tagged molecular marker for functional analysis of OsZIP10 metal transporter gene in rice. Indian J. Genet. Plant Breed. 2018, 78, 180–186. [Google Scholar] [CrossRef]
- Evens, N.P.; Buchner, P.; Williams, L.E.; Hawkesford, M.J. The role of ZIP transporters and group F bZIP transcription factors in the Zn-deficiency response of wheat (Triticum aestivum). Plant J. 2017, 92, 291–304. [Google Scholar] [CrossRef] [PubMed] [Green Version]
- Cakmak, I.; Torun, A.; Millet, E.; Feldman, M.; Fahima, T.; Korol, A.; Nevo, E.; Braun, H.J.; Ozkan, H. Triticum dicoccoides: An important genetic resource for increasing zinc and iron concentration in modern cultivated wheat. Soil Sci. Plant Nutr. 2004, 50, 1047–1054. [Google Scholar] [CrossRef] [Green Version]
- Uauy, C.; Brevis, J.C.; Dubcovsky, J. The high grain protein content gene Gpc-B1 accelerates senescence and has pleiotropic effects on protein content in wheat. J. Exp. Bot. 2006, 57, 2785–2794. [Google Scholar] [CrossRef] [PubMed]
- Liu, J.; Huang, L.; Li, T.X.; Liu, Y.X.; Yan, Z.H.; Tang, G.; Zheng, Y.L.; Liu, D.C.; Wu, B.H. Genome-wide association study for grain micronutrient concentrations in wheat advanced lines derived from wild emmer. Front. Plant Sci. 2021, 12, 792. [Google Scholar] [CrossRef] [PubMed]
- Durmaz, E.; Coruh, C.; Dinler, G.; Grusak, M.A.; Peleg, Z.; Saranga, Y.; Yazici, A.; Ozturk, L.; Cakmak, I.; Budak, H. Expression and cellular localization of ZIP1 transporter under zinc deficiency in wild emmer wheat. Plant Mol. Biol. Rep. 2011, 29, 582–596. [Google Scholar] [CrossRef]
- Avni, R.; Nave, M.; Barad, O.; Baruch, K.; Twardziok, S.O.; Gundlach, H.; Hale, I.; Mascher, M.; Spannagl, M.; Wiebe, K.; et al. Wild emmer genome architecture and diversity elucidate wheat evolution and domestication. Science 2017, 357, 93–97. [Google Scholar] [CrossRef] [Green Version]
- Baltaci, A.K.; Yuce, K. Zinc transporter proteins. Neurochem. Res. 2017, 43, 517–530. [Google Scholar] [CrossRef]
- Hojyo, S.; Fukada, T. Zinc transporters and signaling in physiology and pathogenesis. Arch. Biochem. Biophys. 2016, 611, 43–50. [Google Scholar] [CrossRef]
- Milner, M.; Seamon, J.; Craft, E.; Kochain, L. Transport properties of members of the ZIP family in plants and their role in Zn and Mn homeostasis. J. Exp. Bot. 2013, 64, 369–381. [Google Scholar] [CrossRef] [Green Version]
- Li, S.; Liu, X.; Zhou, X.; Li, Y.; Yang, W.; Chen, R. Improving zinc and iron accumulation in maize grains using the zinc and iron transporter ZmZIP5. Plant Cell Physiol. 2019, 9, 2077–2085. [Google Scholar] [CrossRef]
- Liu, X.S.; Feng, S.J.; Zhang, B.Q.; Wang, M.Q.; Yang, Z.M. OsZIP1 functions as a metal efflux transporter limiting excess zinc, copper and cadmium accumulation in rice. BMC Plant Biol. 2019, 19, 283. [Google Scholar] [CrossRef] [PubMed]
- Ramesh, S.A.; Shin, R.; Eide, D.J.; Schachtman, D.P. Differential metal selectivity and gene expression of two zinc transporters from rice. Plant Physiol. 2003, 133, 126–134. [Google Scholar] [CrossRef] [Green Version]
- Lee, S.; Kim, S.A.; Lee, J.; Guerinot, M.L.; An, G. Zinc deficiency inducible OsZIP8 encodes a plasma membrane-localized zinc transporter in rice. Mol. Cells 2010, 29, 551–558. [Google Scholar] [CrossRef] [PubMed]
- Li, S.; Zhou, X.; Huang, Y.; Zhu, L.; Zhang, S.; Zhao, Y.; Guo, J.; Chen, J.; Chen, R. Identification and characterization of the zinc-regulated transporters, iron-regulated transporter-like protein (ZIP) gene family in maize. BMC Plant Biol. 2013, 13, 114. [Google Scholar] [CrossRef] [PubMed] [Green Version]
- Riaz, M.W.; Lu, J.; Shah, L.; Yang, L.; Chen, C.; Mei, X.D.; Xue, L.; Manzoor, M.A.; Abdullah, M.; Rehman, S.; et al. Expansion and molecular characterization of AP2/ERF gene family in wheat (Triticum aestivum L.). Front. Genet. 2021, 12, 632155. [Google Scholar] [CrossRef] [PubMed]
- Pla, M.; Vilardell, J.; Guiltinan, M.J.; Marcotte, W.R.; Pagès, M. The cis-regulatory element CCACGTGG is involved in ABA and water-stress responses of the maize gene rab28. Plant Mol. Biol. 1993, 21, 259–266. [Google Scholar] [CrossRef] [PubMed]
- Yan, J.H.; Wang, B.A.; Jiang, Y.N.; Cheng, L.J.; Wu, T.L. GmFNSII-controlled soybean flavone metabolism responds to abiotic stresses and regulates plant salt tolerance. Plant Cell Physiol. 2014, 55, 74–86. [Google Scholar] [CrossRef] [Green Version]
- Chen, S.; Qiu, G. Cloning and activity analysis of the promoter of nucleotide exchange factor gene ZjFes1 from the seagrasses zostera japonica. Sci. Rep. 2020, 10, 17291. [Google Scholar] [CrossRef]
- Jenner, C.F. Starch synthesis in the kernel of wheat under high temperature conditions. Aust. J. Plant Physiol. 1994, 21, 791. [Google Scholar] [CrossRef]
- Manzoor, M.A.; Cheng, X.; Li, G.; Su, X.; Abdullah, M.; Cai, Y. Gene structure, evolution and expression analysis of the P-ATPase gene family in Chinese pear (Pyrus bretschneideri). Comput. Biol. Chem. 2020, 88, 107346. [Google Scholar] [CrossRef]
- Almasia, N.I.; Narhirñak, V.; Hopp, H.E.; Vazquez-Rovere, C. Isolation and characterization of the tissue and development-specific potato snakin-1 promoter inducible by temperature and wounding. Electron. J. Biotechnol. 2010, 13, 8–9. [Google Scholar] [CrossRef]
- Zhang, Z.; Dong, J.; Ji, C.; Wu, Y.; Messing, J. NAC-type transcription factors regulate accumulation of starch and protein in maize seeds. Proc. Natl. Acad. Sci. USA 2019, 116, 11223–11228. [Google Scholar] [CrossRef] [PubMed] [Green Version]
- Zhang, J.Y.; Xuan, J.P.; Jia, X.D.; Liu, Y.Z.; Wang, X.; Guo, Z.R. Isolation and expression analysis of MdAPETALA2 gene from Fuji apple. Acta Bot. Boreali-Occident. Sin. 2012, 32, 1309–1315. [Google Scholar]
- Nakabayashi, K.; Okamoto, M.; Koshiba, T.; Kamiya, Y.; Nambara, E. Genome-wide profiling of stored mRNA in Arabidopsis thaliana seed germination: Epigenetic and genetic regulation of transcription in seed. Plant J. 2010, 41, 697–709. [Google Scholar] [CrossRef]
- Yoshihara, T.; Washida, H.; Takaiwa, F. Assessment of common regulatory regions required for the endosperm-specific expression of rice storage protein glutelin genes by hybrid promoters. Plant Sci. 1996, 121, 63–73. [Google Scholar] [CrossRef]
- Chen, W.R.; Feng, Y.; Chao, Y.E. Genomic analysis and expression pattern of OsZIP1, OsZIP3, and OsZIP4 in two rice (Oryza sativa L.) genotypes with different zinc efficiency. Russ. J. Plant Physiol. 2008, 55, 400–409. [Google Scholar] [CrossRef]
- Yamaji, N.; Ma, J.F. The node a hub for mineral nutrient distribution in graminaceous plants. Trends Plant Sci. 2014, 19, 556–563. [Google Scholar] [CrossRef]
- Ramegowda, Y.; Venkategowda, R.; Jagadish, P.; Govind, G.; Hanumanthareddy, R.R.; Makarla, U.; Guligowda, S.A. Expression of a rice Zn transporter, OsZIP1, increases Zn concentration in tobacco and finger millet transgenic plants. Plant Biotechnol. Rep. 2013, 7, 309–319. [Google Scholar] [CrossRef]
- Zhao, H.; Eide, D. The yeast ZRT1 gene encodes the zinc transporter protein of a high-affinity uptake system induced by zinc limitation. Proc. Natl. Acad. Sci. USA 1996, 93, 2454–2458. [Google Scholar] [CrossRef] [Green Version]
- Bird, A.J.; Blankman, E.; Stillman, J.; Eide, D.J.; Winge, D.R. The Zap1 transcriptional activator also acts as a repressor by binding downstream of the TATA box in ZRT2. EMBO J. 2004, 23, 1123–1132. [Google Scholar] [CrossRef] [Green Version]
- Pedas, P.; Schjoerring, J.K.; Husted, S. Identification and characterization of zinc-starvation-induced ZIP transporters from barley roots. Plant Physiol. Biochem. 2009, 47, 377–383. [Google Scholar] [CrossRef] [PubMed]
- Yasuhiro, I.; Hiroshi, M.; Motofumi, S.; Khurram, B.; Michiko, T.; Hiromi, N.; Satoshi, M.; Nishizawa, N.K. Overexpression of the OsZIP4 zinc transporter confers disarrangement of zinc distribution in rice plants. J. Exp. Bot. 2007, 58, 2909. [Google Scholar]
- Li, S.; Liu, Z.H.; Guo, L.L.; Li, H.J.; Nie, X.J.; Chai, S.C.; Zheng, W.J. Genome-wide identification of ZIP gene family members in wheat. Front. Plant Sci. 2021, 12, 2481. [Google Scholar]
- Flicek, P.; Amode, M.R.; Barrell, D.; Beal, K.; Fitzgerald, S. Ensembl 2012. Nucleic Acids Res. 2012, 40, D84–D90. [Google Scholar] [CrossRef] [Green Version]
- Larkin, M.A.; Blackshields, G.; Brown, N.P.; Chenna, R.; McGettigan, P.A.; McWilliam, H.; Valentin, F.; Wallace, I.M.; Wilm, A.; Lopez, R.; et al. Clustal W and Clustal X version 2.0. Bioinformatics 2007, 23, 2947–2948. [Google Scholar] [CrossRef] [Green Version]
- Letunic, I.; Bork, P. Interactive tree of life (iTOL) v4: Recent updates and new developments. Nucleic Acids Res. 2019, 47, W256–W259. [Google Scholar] [CrossRef] [Green Version]
- Chen, C.J.; Chen, H.; Zhang, Y.; Thomas, H.R.; Frank, M.H.; He, Y.H.; Xia, R. TBtools: An integrative toolkit developed for interactive analyses of big biological data. Mol. Plant 2020, 13, 1194–1202. [Google Scholar] [CrossRef]
- Hu, B.; Jin, J.; Guo, A.Y.; Zhang, H.; Luo, J.; Gao, G. GSDS 2.0: An upgraded gene feature visualization server. Bioinformatics 2015, 31, 1296–1297. [Google Scholar] [CrossRef] [Green Version]
- Bailey, T.L.; Mikael, B.; Buske, F.A.; Martin, F.; Grant, C.E.; Luca, C.; Ren, J.; Li, W.W.; Noble, W.S. MEME Suite: Tools for motif discovery and searching. Nucleic Acids Res. 2009, 37, 202–208. [Google Scholar] [CrossRef]
- Rombauts, S.; Dehais, P.; Van Montagu, M.; Rouze, P. Plantcare, a plant cis-acting regulatory element database. Nucleic Acids Res. 1999, 27, 295–296. [Google Scholar] [CrossRef] [Green Version]
- Gong, F.Y.; Qi, T.G.; Zhang, T.; Lu, Y.S.; Liu, J.; Zhong, X.Y.; He, J.S.; Li, Y.F.; Zheng, Y.L.; Liu, D.C.; et al. Comparison of the Agronomic, Cytological, Grain Protein Characteristics, as Well as Transcriptomic Profile of Two Wheat Lines Derived from Wild Emmer. Front. Genet. 2022, 12, 804481. [Google Scholar] [CrossRef] [PubMed]
- Livak, K.J.; Schmittgen, T.D. Analysis of relative gene expression data using real-time quantitative PCR. Methods 2002, 25, 402–408. [Google Scholar] [CrossRef] [PubMed]
- Sasaki, A.; Yamaji, Y.; Yokosho, K.; Ma, J.F. Nramp5 is a major transporter responsible for manganese and cadmium uptake in rice. Plant Cell 2012, 24, 2155–2167. [Google Scholar] [CrossRef] [PubMed] [Green Version]

| Gene | Sequence ID | Chromosome | Protein Length (Amino Acids) | Transmembrane Domain | Isoelectric Point (PI) | Subcellular Location |
|---|---|---|---|---|---|---|
| TdZIP1A-1 | TRIDC1AG014690.1 | 1A | 376 | 8 | 6.79 | Plasma membrane |
| TdZIP1A-2 | TRIDC1AG018050.1 | 1A | 148 | 3 | 7.83 | Plasma membrane |
| TdZIP1A-3 | TRIDC1AG019100.1 | 1A | 577 | 13 | 6.85 | Plasma membrane |
| TdZIP1A-4 | TRIDC1AG044090.1 | 1A | 371 | 9 | 6.26 | Plasma membrane |
| TdZIP1A-5 | TRIDC1AG044100.1 | 1A | 351 | 7 | 6.55 | Plasma membrane |
| TdZIP1B-1 | TRIDC1BG018820.1 | 1B | 395 | 8 | 6.21 | Plasma membrane |
| TdZIP1B-2 | TRIDC1BG022010.1 | 1B | 119 | 3 | 6.91 | Plasma membrane |
| TdZIP1B-3 | TRIDC1BG023900.1 | 1B | 577 | 13 | 7.54 | Plasma membrane |
| TdZIP1B-4 | TRIDC1BG049910.1 | 1B | 359 | 9 | 6.38 | Plasma membrane |
| TdZIP1B-5 | TRIDC1BG049920.3 | 1B | 354 | 7 | 6.36 | Plasma membrane |
| TdZIP2A-1 | TRIDC2AG017840.1 | 2A | 115 | 3 | 7.78 | Plasma membrane |
| TdZIP2A-2 | TRIDC2AG017850.1 | 2A | 68 | 1 | 5.05 | Plasma membrane |
| TdZIP2A-3 | TRIDC2AG061130.1 | 2A | 167 | 5 | 9.8 | Plasma membrane |
| TdZIP2A-4 | TRIDC2AG071150.1 | 2A | 104 | 3 | 9.3 | Plasma membrane |
| TdZIP2B-2 | TRIDC2BG021610.1 | 2B | 170 | 4 | 6.33 | Plasma membrane |
| TdZIP2B-3 | TRIDC2BG064770.1 | 2B | 260 | 3 | 6.89 | Plasma membrane |
| TdZIP2B-4 | TRIDC2BG077000.1 | 2B | 361 | 7 | 6.1 | Plasma membrane |
| TdZIP3A-1 | TRIDC3AG074590.1 | 3A | 383 | 9 | 5.83 | Plasma membrane |
| TdZIP3B-1 | TRIDC3BG085920.1 | 3B | 355 | 9 | 6.59 | Plasma membrane |
| TdZIP4A-1 | TRIDC4AG003470.1 | 4A | 206 | 4 | 6.64 | Plasma membrane |
| TdZIP4B-1 | TRIDC4BG048110.1 | 4B | 365 | 7 | 6.36 | Plasma membrane |
| TdZIP5A-1 | TRIDC5AG039960.1 | 5A | 188 | 5 | 5.2 | Plasma membrane |
| TdZIP5B-1 | TRIDC5BG042350.1 | 5B | 349 | 7 | 9.21 | Plasma membrane |
| TdZIP6A-1 | TRIDC6AG012920.1 | 6A | 358 | 9 | 5.41 | Plasma membrane |
| TdZIP6A-2 | TRIDC6AG022380.1 | 6A | 276 | 8 | 8.73 | Endoplasmic reticulum |
| TdZIP6B-1 | TRIDC6BG018040.1 | 6B | 364 | 9 | 5.28 | Plasma membrane |
| TdZIP6B-2 | TRIDC6BG028970.1 | 6B | 229 | 6 | 8.76 | Endoplasmic reticulum |
| TdZIP6B-3 | TRIDC6BG030420.1 | 6B | 382 | 9 | 5.81 | Plasma membrane |
| TdZIP7A-2 | TRIDC7AG050460.2 | 7A | 366 | 6 | 6.13 | Plasma membrane |
| TdZIP7A-3 | TRIDC7AG058500.1 | 7A | 250 | 3 | 6.21 | Plasma membrane |
| TdZIP7B-1 | TRIDC7BG041340.4 | 7B | 170 | 5 | 5.3 | Endoplasmic reticulum |
| TdZIP7B-2 | TRIDC7BG043370.1 | 7B | 221 | 3 | 6.1 | Plasma membrane |
| TdZIP7B-3 | TRIDC7BG051280.1 | 7B | 162 | 2 | 6.18 | Plasma membrane |
Publisher’s Note: MDPI stays neutral with regard to jurisdictional claims in published maps and institutional affiliations. |
© 2022 by the authors. Licensee MDPI, Basel, Switzerland. This article is an open access article distributed under the terms and conditions of the Creative Commons Attribution (CC BY) license (https://creativecommons.org/licenses/by/4.0/).
Share and Cite
Gong, F.; Qi, T.; Hu, Y.; Jin, Y.; Liu, J.; Wang, W.; He, J.; Tu, B.; Zhang, T.; Jiang, B.; et al. Genome-Wide Investigation and Functional Verification of the ZIP Family Transporters in Wild Emmer Wheat. Int. J. Mol. Sci. 2022, 23, 2866. https://doi.org/10.3390/ijms23052866
Gong F, Qi T, Hu Y, Jin Y, Liu J, Wang W, He J, Tu B, Zhang T, Jiang B, et al. Genome-Wide Investigation and Functional Verification of the ZIP Family Transporters in Wild Emmer Wheat. International Journal of Molecular Sciences. 2022; 23(5):2866. https://doi.org/10.3390/ijms23052866
Chicago/Turabian StyleGong, Fangyi, Tiangang Qi, Yanling Hu, Yarong Jin, Jia Liu, Wenyang Wang, Jingshu He, Bin Tu, Tao Zhang, Bo Jiang, and et al. 2022. "Genome-Wide Investigation and Functional Verification of the ZIP Family Transporters in Wild Emmer Wheat" International Journal of Molecular Sciences 23, no. 5: 2866. https://doi.org/10.3390/ijms23052866
APA StyleGong, F., Qi, T., Hu, Y., Jin, Y., Liu, J., Wang, W., He, J., Tu, B., Zhang, T., Jiang, B., Wang, Y., Zhang, L., Zheng, Y., Liu, D., Huang, L., & Wu, B. (2022). Genome-Wide Investigation and Functional Verification of the ZIP Family Transporters in Wild Emmer Wheat. International Journal of Molecular Sciences, 23(5), 2866. https://doi.org/10.3390/ijms23052866

